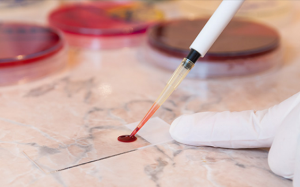
Hy vọng mới cho người bệnh hồng cầu hình liềm

Tin hot
17/10/2016 10:28
Theo Trung tâm Dự báo Khí tượng Thủy văn Trung ương, bão số 7 (bão Sarika) đang có xu hướng di chuyên lệch lên phía Bắc. So với 24h trước thì hiện tại vùng bão đổ bộ được dự báo sẽ...
17/10/2016 06:08
Cự Giải đạt được những thành công lớn. Bọ Cạp gặp nhiều may mắn trong hôm nay.
16/10/2016 16:51
Hầu như mọi đứa trẻ đều thích thú khi được ăn thức ăn trên những que xiên. Bởi vây, tại sao hôm nay bạn không làm cho chúng những xiên thịt gà nướng kebab thơm ngon nhỉ. Rất hấp dẫn...
16/10/2016 07:38
Mưa kỷ lục đã làm ít nhất 8 người chết, 10 người mất tích, giao thông miền Trung tê liệt. Cơ quan Khí tượng dự báo mưa đã giảm nhưng một số nơi vẫn trên 100 mm.
15/10/2016 17:10
Chuyện tình cảm của Sư Tử sẽ có bước tiến đáng kể. Bảo Bình có thể trở nên thụ động hơn.
15/10/2016 09:19
Chào bác sỹ! Tôi năm nay 30 tuổi. Tôi thường bị đau đầu và nghẹt mũi do viêm xoang nhưng sử dụng các loại thuốc dị ứng không thấy có tác dụng. Tôi phải làm thế nào đây, thưa bác sỹ?...
15/10/2016 09:12
Đã bao giờ bạn ăn món sườn rán không ngấm mỡ, miếng thịt mềm tơi không hề bở lại thơm đậm mùi gừng tỏi chưa? Bí quyết đơn giản là bọc sườn trong giấy nến rồi rán trong chảo...
14/10/2016 14:40
Lần đầu tiên, các nhà khoa học đã chỉnh sửa thành công các đột biến ở tế bào gốc đủ để tạo ra một lợi ích đáng kể cho những người bị bệnh hồng cầu hình liềm.
14/10/2016 14:21
Thèm ăn vô độ, ra mồ hôi nhiều, nhịp tim đập nhanh và tăng huyết áp chỉ là một vài biểu hiện nổi tiếng của stress tới cơ thể con người. Ngoài những triệu chứng rõ ràng trên, tình...
14/10/2016 13:41
Sau khi sinh con, đặc biệt là trong thời gian cho con bú, nhiều chị em bỏ bê chồng, không còn quan tâm hay ham muốn tình dục như xưa nữa. Ngoài việc bận rộn khi phải chăm sóc em bé ra, có chuyện gì...